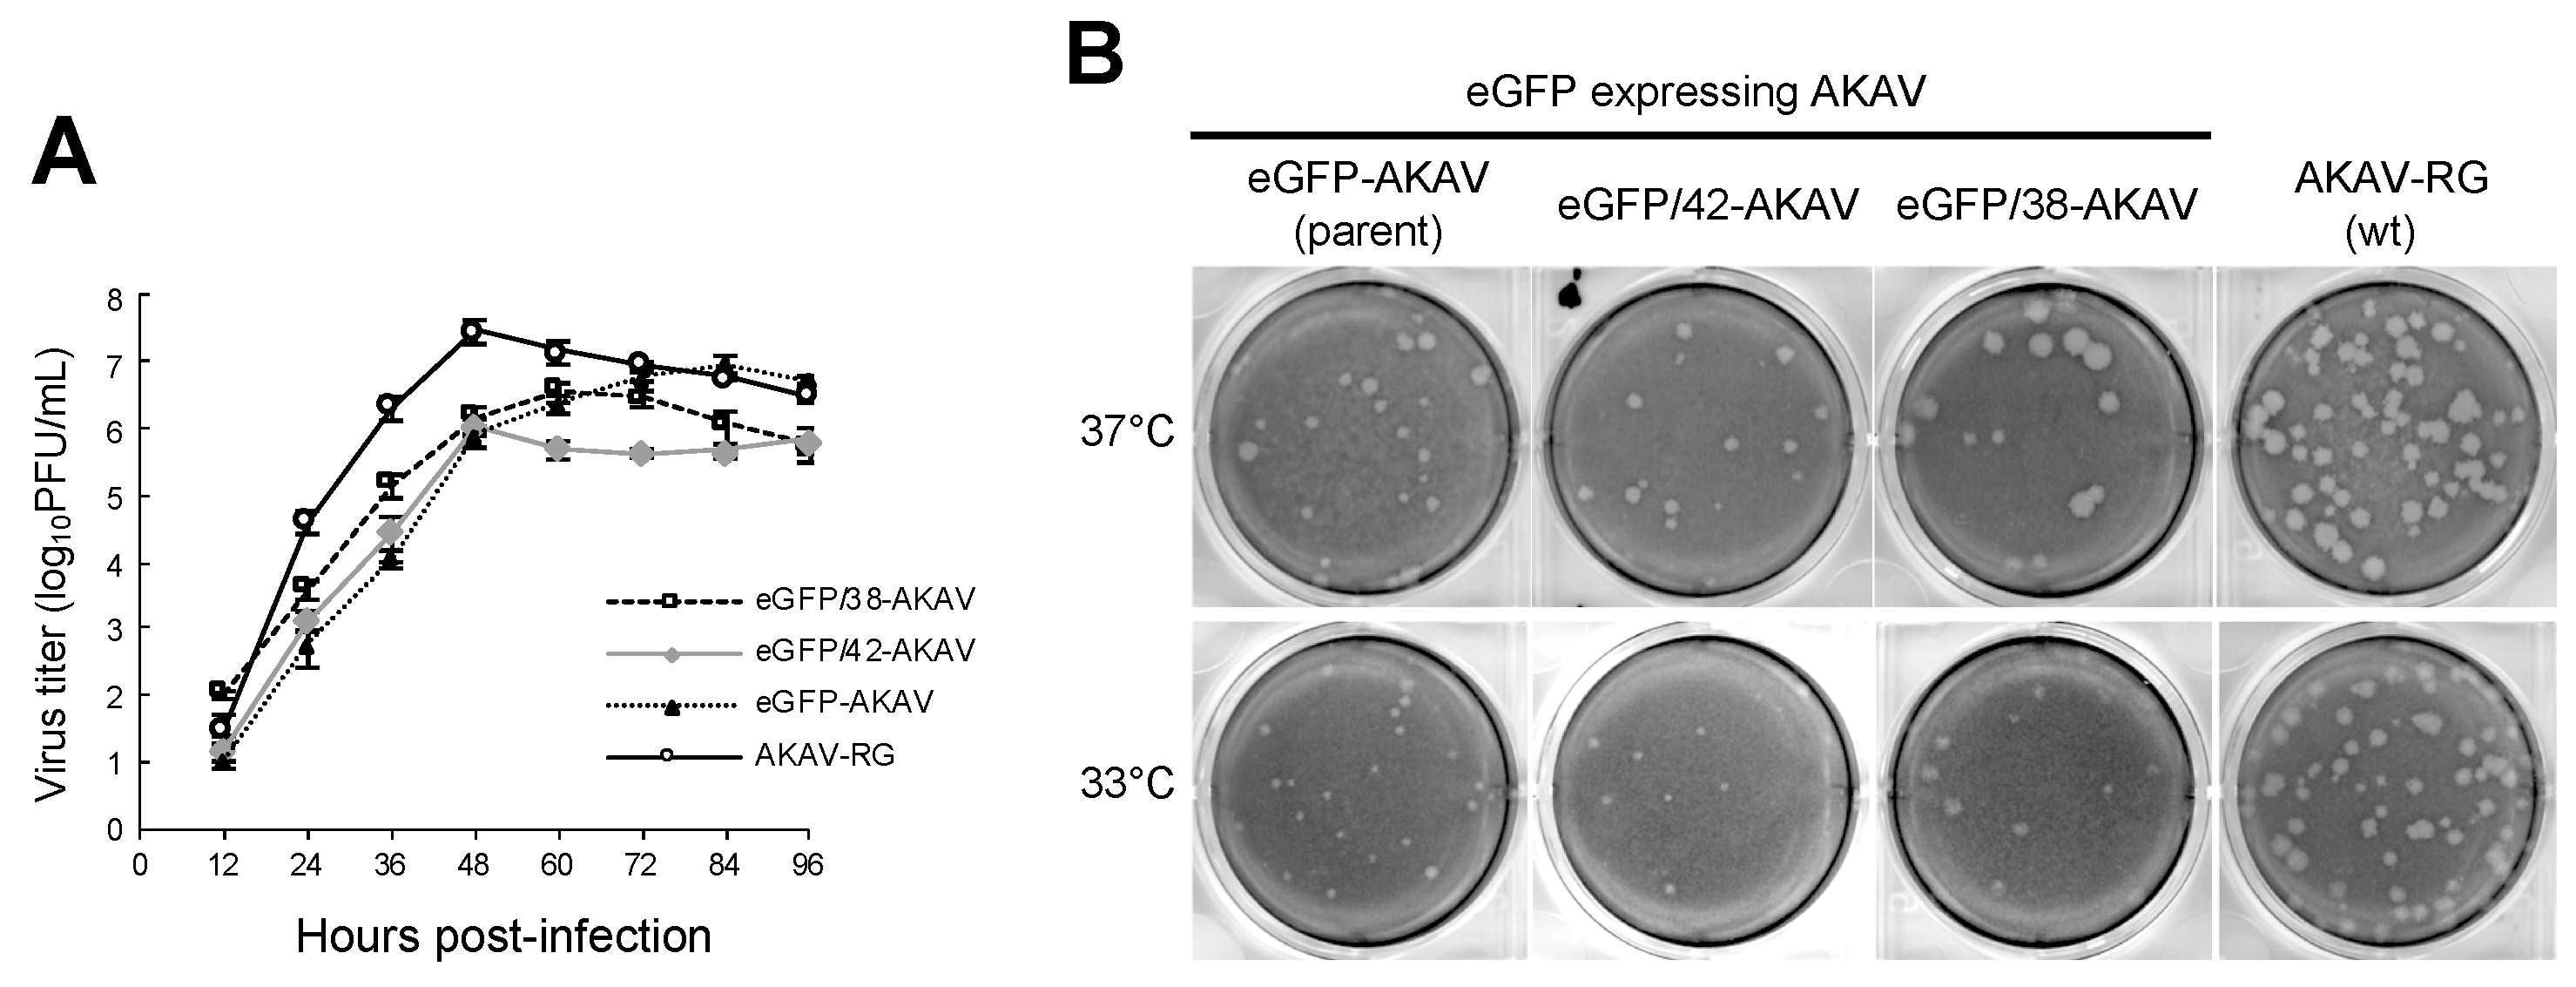
Viruses 11 00634 g002

Generation of a GFP Reporter Akabane Virus with Enhanced Fluorescence Intensity by Modification of Artificial Ambisense S Genome
Abstract
1. Introduction
2. Materials and Methods
2.1. Cells and Viruses
2.2. Plasmid Construction
2.3. Reverse Genetics
2.4. Counting GFP-Positive Plaques
2.5. Growth Kinetics and Plaque Morphology
2.6. Immunofluorescence Assays
2.7. Northern Blotting
2.8. Quantitative Real-Time PCR
2.9. Animal Experiments with Bioimaging and Histopathological Analyses
3. Results
3.1. Generation of Recombinant Reporter AKAVs with 5′ UTR Partial Deletions of S Segment
3.2. In Vitro Growth Property of eGFP/38-AKAV
3.3. Replication and Transcription of Ambisense S Segment RNA in Recombinant Virus-Infected Cells
3.4. Pathogenicity of eGFP/38-AKAV in Mice
3.5. Fluorescence Imaging of the Central Nervous System (CNS) in eGFP/38-AKAV-Infected Mice
4. Discussion
Author Contributions
Funding
Acknowledgments
Conflicts of Interest
References
- Ishihara, Y.; Shioda, C.; Bangphoomi, N.; Sugiura, K.; Saeki, K.; Tsuda, S.; Iwanaga, T.; Takenaka-Uema, A.; Kato, K.; Murakami, S.; et al. Akabane virus nonstructural protein NSm regulates viral growth and pathogenicity in a mouse model. J. Vet. Med. Sci. 2016, 78, 1391–1397. [Google Scholar] [CrossRef] [PubMed]
- Weber, F.; Bridgen, A.; Fazakerley, J.K.; Streitenfeld, H.; Kessler, N.; Randall, R.E.; Elliott, R.M. Bunyamwera bunyavirus nonstructural protein NSs counteracts the induction of alpha/beta interferon. J. Virol. 2002, 76, 7949–7955. [Google Scholar] [CrossRef] [PubMed]
- Fuller, F.; Bhown, A.S.; Bishop, D.H. Bunyavirus nucleoprotein, N, and a non-structural protein, NSS, are coded by overlapping reading frames in the S RNA. J. Gen. Virol. 1983, 64, 1705–1714. [Google Scholar] [CrossRef] [PubMed]
- Lowen, A.C.; Elliott, R.M. Mutational analyses of the nonconserved sequences in the Bunyamwera Orthobunyavirus S segment untranslated regions. J. Virol. 2005, 79, 12861–12870. [Google Scholar] [CrossRef] [PubMed]
- Pettersson, R.F.; von Bonsdorff, C.H. Ribonucleoproteins of Uukuniemi virus are circular. J. Virol. 1975, 15, 386–392. [Google Scholar] [PubMed]
- Samso, A.; Bouloy, M.; Hannoun, C. Circular ribonucleoproteins in the virus Lumbo (Bunyavirus). Comptes R. Acad. Sci. Hebd. Seances Acad. Sci. Ser. D 1975, 280, 779–782. [Google Scholar]
- Obijeski, J.F.; Bishop, D.H.; Palmer, E.L.; Murphy, F.A. Segmented genome and nucleocapsid of La Crosse virus. J. Virol. 1976, 20, 664–675. [Google Scholar] [PubMed]
- Raju, R.; Kolakofsky, D. The ends of La Crosse virus genome and antigenome RNAs within nucleocapsids are base paired. J. Virol. 1989, 63, 122–128. [Google Scholar]
- Flick, K.; Katz, A.; Overby, A.; Feldmann, H.; Pettersson, R.F.; Flick, R. Functional analysis of the noncoding regions of the Uukuniemi virus (Bunyaviridae) RNA segments. J. Virol. 2004, 78, 11726–11738. [Google Scholar] [CrossRef]
- Barr, J.N.; Rodgers, J.W.; Wertz, G.W. The Bunyamwera virus mRNA transcription signal resides within both the 3’ and the 5’ terminal regions and allows ambisense transcription from a model RNA segment. J. Virol. 2005, 79, 12602–12607. [Google Scholar] [CrossRef]
- Barr, J.N.; Wertz, G.W. Role of the conserved nucleotide mismatch within 3’- and 5’-terminal regions of Bunyamwera virus in signaling transcription. J. Virol. 2005, 79, 3586–3594. [Google Scholar] [CrossRef] [PubMed]
- Takenaka-Uema, A.; Murata, Y.; Gen, F.; Ishihara-Saeki, Y.; Watanabe, K.; Uchida, K.; Kato, K.; Murakami, S.; Haga, T.; Akashi, H.; et al. Generation of a recombinant Akabane virus expressing enhanced green fluorescent protein. J. Virol. 2015, 89, 9477–9484. [Google Scholar] [CrossRef] [PubMed]
- Van Knippenberg, I.; Elliott, R.M. Flexibility of bunyavirus genomes: Creation of an orthobunyavirus with an ambisense s segment. J. Virol. 2015, 89, 5525–5535. [Google Scholar] [CrossRef] [PubMed][Green Version]
- Albariño, C.G.; Bird, B.H.; Nichol, S.T. A shared transcription termination signal on negative and ambisense RNA genome segments of Rift Valley fever, sandfly fever Sicilian, and Toscana viruses. J. Virol. 2007, 81, 5246–5256. [Google Scholar] [CrossRef] [PubMed]
- Ikegami, T.; Won, S.; Peters, C.J.; Makino, S. Characterization of Rift Valley fever virus transcriptional terminations. J. Virol. 2007, 81, 8421–8438. [Google Scholar] [CrossRef] [PubMed]
- Lara, E.; Billecocq, A.; Leger, P.; Bouloy, M. Characterization of wild-type and alternate transcription termination signals in the Rift Valley fever virus genome. J. Virol. 2011, 85, 12134–12145. [Google Scholar] [CrossRef] [PubMed]
- Blakqori, G.; Lowen, A.C.; Elliott, R.M. The small genome segment of Bunyamwera orthobunyavirus harbours a single transcription-termination signal. J. Gen. Virol. 2012, 93, 1449–1455. [Google Scholar] [CrossRef]
- Coupeau, D.; Claine, F.; Wiggers, L.; Martin, B.; Kirschvink, N.; Muylkens, B. Characterization of messenger RNA termini in Schmallenberg virus and related Simbuviruses. J. Gen. Virol. 2013, 94, 2399–23405. [Google Scholar] [CrossRef]
- Ito, N.; Takayama-Ito, M.; Yamada, K.; Hosokawa, J.; Sugiyama, M.; Minamoto, N. Improved recovery of rabies virus from cloned cDNA using a vaccinia virus-free reverse genetics system. Microbiol. Immunol. 2003, 47, 613–617. [Google Scholar] [CrossRef]
- Miyazato, S.; Miura, Y.; Hase, M.; Kubo, M.; Goto, Y.; Kono, Y. Encephalitis of cattle caused by Iriki isolate, a new strain belonging to Akabane virus. Jpn. J. Vet. Sci. 1989, 51, 128–136. [Google Scholar] [CrossRef]
- Takenaka-Uema, A.; Sugiura, K.; Bangphoomi, N.; Shioda, C.; Uchida, K.; Kato, K.; Haga, T.; Murakami, S.; Akashi, H.; Horimoto, T. Development of an improved reverse genetics system for Akabane bunyavirus. J. Virol. Methods 2016, 232, 16–20. [Google Scholar] [CrossRef] [PubMed]
- Habjan, M.; Penski, N.; Spiegel, M.; Weber, F. T7 RNA polymerase-dependent and -independent systems for cDNA-based rescue of Rift Valley fever virus. J. Gen. Virol. 2008, 89, 2157–2166. [Google Scholar] [CrossRef] [PubMed]
- Ogawa, Y.; Sugiura, K.; Kato, K.; Tohya, Y.; Akashi, H. Rescue of Akabane virus (family Bunyaviridae) entirely from cloned cDNAs by using RNA polymerase I. J. Gen. Virol. 2007, 88, 3385–3390. [Google Scholar] [CrossRef] [PubMed]
- Akashi, H.; Inaba, Y. Antigenic diversity of Akabane virus detected by monoclonal antibodies. Virus Res. 1997, 47, 187–196. [Google Scholar] [CrossRef]
- Kurogi, H.; Inaba, Y.; Takahashi, E.; Sato, K.; Omori, T.; Miura, Y.; Goto, Y.; Fujiwara, Y.; Hatano, Y.; Kodama, K.; et al. Epizootic congenital arthrogryposis-hydranencephaly syndrome in cattle: Isolation of Akabane virus from affected fetuses. Arch. Virol. 1976, 51, 67–74. [Google Scholar] [CrossRef] [PubMed]
- Tsuda, T.; Yoshida, K.; Yanase, T.; Ohashi, S.; Yamakawa, M. Competitive enzyme-linked immunosorbent assay for the detection of the antibodies specific to akabane virus. J. Vet. Diagn. Investig. 2004, 16, 571–576. [Google Scholar] [CrossRef] [PubMed]
- Cook, S.H.; Griffin, D.E. Luciferase imaging of a neurotropic viral infection in intact animals. J. Virol. 2003, 77, 5333–5338. [Google Scholar] [CrossRef]
- De Swart, R.L.; Ludlow, M.; de Witte, L.; Yanagi, Y.; van Amerongen, G.; McQuaid, S.; Yüksel, S.; Geijtenbeek, T.B.; Duprex, W.P.; Osterhaus, A.D. Predominant infection of CD150+ lymphocytes and dendritic cells during measles virus infection of macaques. PLoS Pathog. 2007, 3, e178. [Google Scholar] [CrossRef]
- Manicassamy, B.; Manicassamy, S.; Belicha-Villanueva, A.; Pisanelli, G.; Pulendran, B.; García-Sastre, A. Analysis of in vivo dynamics of influenza virus infection in mice using a GFP reporter virus. Proc. Natl. Acad. Sci. USA 2010, 107, 11531–11536. [Google Scholar] [CrossRef]
- Gommet, C.; Billecocq, A.; Jouvion, G.; Hasan, M.; Zaverucha do Valle, T.; Guillemot, L.; Blanchet, C.; van Rooijen, N.; Montagutelli, X.; Bouloy, M.; et al. Tissue tropism and target cells of NSs-deleted rift valley fever virus in live immunodeficient mice. PLoS Negl. Trop. Dis. 2011, 5, e1421. [Google Scholar] [CrossRef]
- Ludlow, M.; Nguyen, D.T.; Silin, D.; Lyubomska, O.; de Vries, R.D.; von Messling, V.; McQuaid, S.; De Swart, R.L.; Duprex, W.P. Recombinant canine distemper virus strain Snyder Hill expressing green or red fluorescent proteins causes meningoencephalitis in the ferret. J. Virol. 2012, 86, 7508–7519. [Google Scholar] [CrossRef] [PubMed]
- Fukuyama, S.; Katsura, H.; Zhao, D.; Ozawa, M.; Ando, T.; Shoemaker, J.E.; Ishikawa, I.; Yamada, S.; Neumann, G.; Watanabe, S.; et al. Multi-spectral fluorescent reporter influenza viruses (Color-flu) as powerful tools for in vivo studies. Nat. Commun. 2015, 6, 6600. [Google Scholar] [CrossRef] [PubMed]
- Mazel-Sanchez, B.; Elliott, R.M. Attenuation of bunyamwera orthobunyavirus replication by targeted mutagenesis of genomic untranslated regions and creation of viable viruses with minimal genome segments. J. Virol. 2012, 86, 13672–13678. [Google Scholar] [CrossRef] [PubMed]
- Uchida, K.; Murakami, T.; Sueyoshi, M.; Tsuda, T.; Inai, K.; Acorda, J.A.; Yamaguchi, R.; Tateyama, S. Detection of Akabane viral antigens in spontaneous lymphohistiocytic encephalomyelitis in cattle. J. Vet. Diagn. Invest. 2000, 12, 518–524. [Google Scholar] [CrossRef]
- Lee, J.K.; Park, J.S.; Choi, J.H.; Park, B.K.; Lee, B.C.; Hwang, W.S.; Kim, J.H.; Jean, Y.H.; Haritani, M.; Yoo, H.S.; et al. Encephalomyelitis associated with akabane virus infection in adult cows. Vet. Pathol. 2002, 39, 269–273. [Google Scholar] [CrossRef] [PubMed]
- Kono, R.; Hirata, M.; Kaji, M.; Goto, Y.; Ikeda, S.; Yanase, T.; Kato, T.; Tanaka, S.; Tsutsui, T.; Imada, T.; et al. Bovine epizootic encephalomyelitis caused by Akabane virus in southern Japan. BMC Vet. Res. 2008, 4, 20. [Google Scholar] [CrossRef] [PubMed]
- Kamata, H.; Inai, K.; Maeda, K.; Nishimura, T.; Arita, S.; Tsuda, T.; Sato, M. Encephalomyelitis of cattle caused by Akabane virus in southern Japan in 2006. J. Comp. Pathol. 2009, 140, 187–193. [Google Scholar] [CrossRef] [PubMed]
- Oem, J.K.; Lee, K.H.; Kim, H.R.; Bae, Y.C.; Chung, J.Y.; Lee, O.S.; Roh, I.S. Bovine epizootic encephalomyelitis caused by Akabane virus infection in Korea. J. Comp. Pathol. 2012, 147, 101–105. [Google Scholar] [CrossRef]

© 2019 by the authors. Licensee MDPI, Basel, Switzerland. This article is an open access article distributed under the terms and conditions of the Creative Commons Attribution (CC BY) license (http://creativecommons.org/licenses/by/4.0/).
Share and Cite
Takenaka-Uema, A.; Murakami, S.; Ushio, N.; Kobayashi-Kitamura, T.; Uema, M.; Uchida, K.; Horimoto, T. Generation of a GFP Reporter Akabane Virus with Enhanced Fluorescence Intensity by Modification of Artificial Ambisense S Genome. Viruses 2019, 11, 634. https://doi.org/10.3390/v11070634
Takenaka-Uema A, Murakami S, Ushio N, Kobayashi-Kitamura T, Uema M, Uchida K, Horimoto T. Generation of a GFP Reporter Akabane Virus with Enhanced Fluorescence Intensity by Modification of Artificial Ambisense S Genome. Viruses. 2019; 11(7):634. https://doi.org/10.3390/v11070634
Chicago/Turabian StyleTakenaka-Uema, Akiko, Shin Murakami, Nanako Ushio, Tomoya Kobayashi-Kitamura, Masashi Uema, Kazuyuki Uchida, and Taisuke Horimoto. 2019. "Generation of a GFP Reporter Akabane Virus with Enhanced Fluorescence Intensity by Modification of Artificial Ambisense S Genome" Viruses 11, no. 7: 634. https://doi.org/10.3390/v11070634
APA StyleTakenaka-Uema, A., Murakami, S., Ushio, N., Kobayashi-Kitamura, T., Uema, M., Uchida, K., & Horimoto, T. (2019). Generation of a GFP Reporter Akabane Virus with Enhanced Fluorescence Intensity by Modification of Artificial Ambisense S Genome. Viruses, 11(7), 634. https://doi.org/10.3390/v11070634

